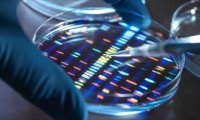
Великобритания запускает революционный проект по созданию искусственной ДНК человека

Что изменится в жизни россиян с июля этого года
За услуги ЖКХ будем платить больше, банковские переводы попадут под налоговый контроль, новые ограничения при выдаче ипотеки, открытие социальных вкладов.

За услуги ЖКХ будем платить больше, банковские переводы попадут под налоговый контроль, новые ограничения при выдаче ипотеки, открытие социальных вкладов.

26 июня 2025 года в Липецке состоялось заседание Правления Российского Союза строителей (РСС). Площадкой для заседания стала Липецкая трубная компания "Свободный сокол".

Новое исследование показало, что переработанные пластиковые бутылки выделяют в воду десятки опасных химических веществ, включая пестициды и лекарства, которые могут нарушать обмен веществ и...
Британские учёные приступили к созданию искусственной ДНК человека — революционный проект SynHG открывает новые горизонты в медицине, но ставит человечество перед сложными этическими дилеммами.